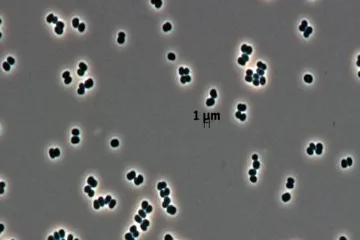

NASA articles

Did NASA discover bacteria that can play dead?
Did NASA discover a bacteria that can play dead?

What is the shape of the universe according to NASA?

What did NASA say about the ocean?

What kind of chemists work at NASA?

How much does NASA pay astrochemistry?

Why did NASA stop to explore the ocean?

What is radial velocity NASA?

How many hours are in a day in NASA?
